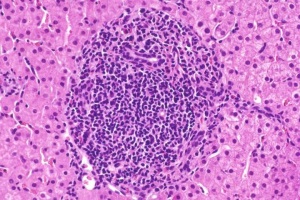

цитомегаловирус м
Вопросы и ответы по: цитомегаловирус м
1. Выкидыш на сроке 4 мес в 2006 году был спровоцирован листериозом – инфекционным заболеванием, возбудитель которого был выявлен у вас при обследовании;
2. Вы являетесь носителем вирусного гепатита В и цитомегаловируса – эти инфекции могут быть причиной привычного невынашивания; положительный результат исследования на краснуху свидетельствует перенесенном заболевании и сформированном пожизненном иммунитете;
3. Гормональный профиль – в норме; УЗИ органов малого таза - в норме; УЗИ внутренних органов – признаки хронического холецистита;
Для выяснения причины нарушения цикла и привычного невынашивания необходимы консультация инфекциониста (для уточнения диагнозов цитомегаловирусная инфекция и носительство гепатита В), эндокринолога (с исследованием гормонов щитовидной железы- для исключения заболеваний щитовидной железы кА источника всех проблем), консультация медицинского генетика. Будьте здоровы!
Заранее благодарна.
В Вашем случае положительны результаты анализов по каждому из возбудителей, то есть ранее Вы уже сталкивались с токсоплазмами, краснухой, ЦМВ и ВПГ ½.
Но на данный момент говорить о наличии заболевании (инфекции, вызванной любым из этих возбудителей) нельзя, как нельзя говорить и о том, что какой-то из этих возбудителей мог стать причиной выкидыша. К тому же сейчас, спустя пол года после случившегося, если и был какой-то инфекционный процесс, мы этого не определим. Причину прерывания нужно было искать сразу же, еще в мае, по горячим следам. Сейчас Вам нужно полноценно обследоваться, чтобы быть полностью спокойной при подготовке к зачатию и в течении следующей беременности. Итак, Вам необходимо методом ИФА провести анализ крови на IgM к токсоплазмам, ЦМВ, ВПГ ½ и вирусу краснухи, методом ПЦР анализ крови (токсоплазмы, ЦМВ, ВПГ ½, вирус краснухи), мочи (токсоплазмы, ЦМВ), слюны (ЦМВ) на ДНК/РНК возбудителей. Если дополнительные исследования дадут отрицательный результат, значит у Вас стойкий пожизненный иммунитет к токсоплазмам и вирусу краснухи (больше никогда не заболеете, обследоваться и лечиться больше не нужно), а ВПГ ½ и ЦМВ, носителем которых Вы являетесь, в данное время не активны, то есть вреда ни Вам, ни будущему малышу причинить не могут. Во время следующей беременности активность ВПГ ½ и ЦМВ (по указанной схеме) нужно проверять в каждом триместре. Если результаты исследований будут другими, обращайтесь с результатами за повторной консультацией. Будьте здоровы!
АТ IgG к токсоплазм. 104 МЕ/мл (менее 7,2 - отрицательный, от 7,2 до 8.8 - сомнительный, более 8.8 - положительный)
АТ IgМ к токсоплазм. 3,6 ОЕ/мл (менее 6 - отрицательный, от 6 до 10 - сомнительный, более 11 - положительный)
АТ IgG к краснухе 38,1 МЕ/мл (менее 9 - отрицательный, от 9 до 11 - сомнительный, более 11 - положительный)
АТ IgМ к краснухе <10 OЕ/мл (менее 20 - отрицательный, от 20 до 25 - сомнительный, более 25 - положительный)
АТ IgG к цитомегаловирусу 8,9 МЕ/мл (менее 0,4 - отрицательный, от 0,4до 0,6 - сомнительный, более 0,6 - положительный)
АТ IgМ к цитомегаловирусу <8 OЕ/мл (менее 15 - отрицательный, от 15 до 30 - сомнительный, более 30 - положительный)
АТ IgG к HSV 1/2 >30 инд (менее 0,9 - отрицательный, от 0,9до 1,1 - сомнительный, более 1,1 - положительный)
АТ IgМ к HSV 1/2 <0.5 инд (менее 0,9 - отрицательный, от 0,9до 1,1 - сомнительный, более 1,1 - положительный)
Большое спасибо.
У Вас хорошие результаты анализов. Антитела Ig М к ТОРЧ-инфекциям отрицательные, так и должно быть, поскольку положительные Ig М – это результат первичного инфицирования или результат реактивации той или иной инфекции, что нежелательно при беременности. Антитела IgG – положительные и это свидетельствует о наличии стойкого защитного иммунитета к ТОРЧ-инфекциям.
Удачи Вам!
Перед беременностью сдала анализы на инфекции
Результаты такие:
Антитела lgG к Toxoplazma gondii CLIA - 47.9 МЕ/мл
Антитела lgG к Цитомегаловирусу (CMV) CLIA - >22 МЕ/мл
Антитела lgG к вирусу краснухи CLIA - 42.2 МЕ/мл
Антитела lgG к HSV 1/2 CLIA - 25.5 Индекс
Во всех случаеях указано, что это положительный результат. Только вот непонятно положительный в смысле, что у меня высокое содержание в крови этих инфекций и их надо лечить? либо раз антитела, то наоборот есть имунитет и мне эти инфекции не страшны? очень хочется забеременеть, а тут куча инфекций нашлась... Подскажите что все таки говорит результат анализа? нужно ли лечение перед беременностью?
герпевирус - позит. 68ДИ (N<9); цитомегаловирус - позит. 93ДИ
(N<9); токсоплазма - позит.>100 (N 48); краснуха - позит. >100 (N40).
Заранее спасибо!
отрицательны - все в полном порядке и для ребенка не опасно.
вот ,а ищо у меня в крові (на ТОРЧ)обнаружили хроничний герпес G-3.6пры норме 0.2 и цитомегаловирус G-3.1пры норме 0.2!я очень безпакоюсь как ето влияет на ребонка,и что можна принеиать,а что не желательно!
Я беременна, 25 неделя. У меня обнаружили цитомегаловирус и уреоплазму. Мой врач сказала, что на моем сроке уже можно и нужно пролечиться. Назначила: Протефлазит; азитрокс 6 дней по 500 мг; Бифи-форм 1 к. 2 раза в день, 15 дней; свечи Мирратин комби 10 дней; свечи Лаферобион 500 тыс - 10 дней; эсливер форте 2 к по 3 раза в день, 10 дней.
Подскажите пожалуйста, насколько все это необходимо пить. Я не сторонница лекарственных препаратов, никогда не принимала антибиотики, и просто обалдела от такого количества лекарств.
Заранее спасибо за ответ.
Популярные статьи на тему: цитомегаловирус м

Одно из первых мест в изучении инфекций ТОRСН-комплекса занимает цитомегаловирусная инфекция (ЦМВИ). В мире цитомегаловирусом (ЦМВ) инфицируется до 2% новорожденных и 45-60% детей в первый год жизни. К тому же, по данным ВОЗ, выявление антител к ЦМВ...

Эзофагит – воспалительное заболевание слизистой оболочки пищевода, вызванное воздействием различных инфекционных и неинфекционных факторов (в т. ч. ЛС). Этиология Инфекционные эзофагиты подразделяют на вирусные (вирус герпеса и цитомегаловирус),...
Хронический гепатит – хронический полиэтиологический воспалительно-деструктивный процесс в печени длительностью свыше 6 месяцев с сохранением дольковой структуры печени. К этиологическим факторам развития хронических гепатитов относят вирусы гепатита...

17 апреля 2007 г. в рамках конгресса «Человек и лекарство» состоялся научно-практический симпозиум, посвященный вопросам оптимизации терапии различных аллергических заболеваний у детей, в частности таких распространенных патологий, как атопический...

В последнее время наиболее актуальными являются междисциплинарные проблемы, возникающие на стыке нескольких медицинских специальностей.

Респираторная патология с рецидивирующим течением у детей раннего возраста приобретает в нашей стране все большую актуальность. Предупреждение формирования рецидивирующего обструктивного бронхита является непростой задачей для каждого педиатра.

Пневмония – распространенное заболевание органов дыхания, встречающееся у 3-15 человек на 1000 населения.

Начало изучения миокардита относится ко второй половине XIX века, термин «миокардит» был предложен G. Sobernheim в 1837 г. В то время считали, что основными признаками заболевания являются инфекционное начало, воспаление миокарда и острые...

В настоящее время за бактериями Helicobacter pylori (H. pylori) укрепилась характеристика медленной «терапевтической» инфекции, поражающей органы-мишени – желудок и двенадцатиперстную кишку.
Новости на тему: цитомегаловирус м

Очень распространенной причиной для неврологических отклонений у младенцев является инфицирование циотомегаловирусом в утробе матери. Теперь появилась надежда на предотвращение этого заболевания с помощью новой вакцины. Исследование, напечатанное в журнале New England Journal of Medicine, сообщает, что новая прививка против цитомегаловируса уменьшает количество случаев инфицирования женщин и потенциально может уменьшить риск врожденной инфекции у младенцев.

Хронические запоры являются серьезной проблемой для миллионов жителей планеты. К сожалению, во многих случаях причину заболевания установить не удается. А ученые обнаружили, что запоры могут быть вызваны вирусом герпеса, проникшим в ткани кишечника.

Наблюдаемый в последнее 10-15 лет повышенный интерес ученых к проблеме старческой деменции объясняется ускоренным ростом числа больных, страдающих этим заболеванием. А ученые из США обнаружили сразу несколько новых факторов риска развития деменции.

Дефицит донорских органов в тех странах, где операции по их пересадке поставлены на поток, привел к появлению печального явления – так называемому «трансплантационному туризму». Но качество операций в центрах такого туризма неудовлетворительное.

В последние годы в США и странах Западной Европы наблюдается настоящий бум необычного бизнеса – продажи грудного молока через Интернет. Однако ученые предупреждают о том, что такое молоко может нанести серьезный вред здоровью ребенка.

Возможности современных «умных» мобильных телефонов не перестают поражать воображение – ученые из США превратили смартфон в мощный микроскоп. Благодаря небольшой насадке, устройство способно различать объекты в 1 000 раз тоньше человеческого волоса.

Врожденная гидроцефалия не является очень редким заболеванием, однако у индийской девочки водянка головного мозга протекает особенно тяжело. Денег на лечение дочери у ее родителей нет, и ребенок был бы обречен, если бы не помощь добрых людей.

В организме человека болезнетворные микробы и вирусы, благодаря усилиям иммунной системы, часто обитают незаметно, никак не проявляя себя. Но и в «укрощенном» виде они могут производить разрушительную работу – ухудшая, например, интеллект.

Артериальная гипертензия стала проклятием современного общества с его безумным темпом жизни, питанием фатсфудом и стрессами. Однако помимо уже известных причин гипертонии есть и другие: ученые из Китая выявили, что недуг могут вызывать и вирусы.




